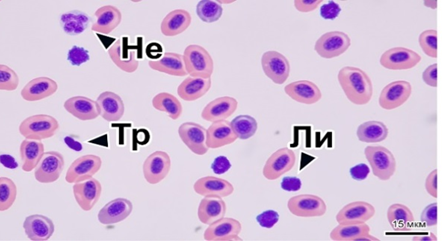

Россия
Россия
Россия
Россия
Россия
Россия
Россия
УДК 639.3.043.2 Корма
Исследовалась эффективность применения гаприна (белка микробиологического синтеза, торговая марка «Инноприн») в качестве частичной замены рыбной муки в составе комбикормов для радужной форели (Oncorhynchus mykiss). Замена производилась в количестве 4 и 7 % от полной массы корма. Сравнение производилось по отношению к рецептурам без биосинтетических белков, в том числе без спиртовых или пивных дрожжей. Введение 4 % гаприна позволило снизить стоимость комбикормов и улучшить рыбоводно-биологические показатели, при этом ввод 7 % гаприна привел к большему снижению стоимости, но ухудшил рыбоводно-биологические показатели и оказал негативное влияние на состояние внутренних органов и крови исследуемых особей. В гистологических препаратах тканей кишечника и печени контрольной группы и группы с вводом 4 % гаприна не было обнаружено значимых морфологических изменений. В группе с вводом 7 % гаприна выявлены значительные нарушения структуры тканей кишечника и печени. Введение 4 % гаприна в состав комбикормов для радужной форели не приводит к повышенной смертности и не имеет токсикологических эффектов. Негативное влияние повышенных концентраций гаприна на радужную форель, вероятно, обусловлено высоким содержанием в нем меди и цинка, что может приводить к нарушениям структуры органов пищеварения.
аквакультура, гаприн, белок микробиологического синтеза, белок микробного происхождения, садковое выращивание, гематология
Введение
Cадковое выращивание радужной форели в пресноводных водоемах РФ требует значительных затрат на кормление рыбы. В некоторых случаях доля расходов на приобретение кормов составляет 50–60 % от себестоимости выращивания рыбы [1]. Качественные гранулированные корма содержат в своем составе рыбную муку, обеспечивающую полноценный нутриентный состав и высокую скорость роста форели [2]. Существенным недостатком рыбной муки является ее высокая стоимость и нестабильное качество, которое зависит от вида сырья [3]. В связи с этим комбикормовые предприятия вынуждены осуществлять поиск доступных высокоэффективных компонентов для производства комбикормов, позволяющих обеспечить организм рыбы необходимыми питательными и биологически активными веществами, а также белками высокого качества [4, 5]. Для обеспечения организма рыб белками в состав комбикормов вводят различные продукты животного, растительного, а также микробного и химического происхождения [6]. Одним из таких продуктов является гаприн.
Гаприн представляет собой биомассу метанокисляющих бактерий Methylococcus capsulatus [7]. Этим бактериям свойственна очень высокая скорость размножения и синтеза белка, что делает их ценным объектом для производства кормового белка. Основным углеродным субстратом для этих бактерий является природный газ, состоящий преимущественно из метана. Комплексные исследования, проведенные в различных институтах и производственных площадках, позволили доказать эффективность гаприна как высокоценного белкового сырья [8]. Аминокислотный профиль гаприна близок к потребностям радужной форели, при этом он может варьироваться в соответствии с различными технологиями производств [9].
Целью исследований является оценка эффективности использования гаприна в составе комбикормов на годовиках радужной форели в условиях садкового выращивания в акватории Ладожского озера.
Материалы и методы
Исследования выполнялись в условиях рыбоводного предприятия ООО «Ладожская форель» (Республика Карелия) осенью 2023 г. В качестве объекта исследований использовали годовиков радужной форели породы Дональдсона, выведенных из икры Aquasearch Fresh (Дания), средней массой 300 г. Выращивание рыбы производили в садках диаметром 12,7 м, установленных в акватории Ладожского озера. Для эксперимента было использовано 45 000 особей радужной форели (Oncorhynchus mykiss), которые были разделены на 3 группы: 2 опыта и контроль. Кормление рыб осуществляли вручную дважды в день, при этом рацион в равных долях делился на вечернее и утреннее кормление. Суточный рацион рассчитывали в зависимости от биомассы и температуры воды по специальным кормовым таблицам. Измерения проводились с использованием оксиметра Milwaukee MW605 MAX и электронного термометра ТП700 с погрешностью измерений в 1 °C. Средний вес определялся на платформенных весах ВСП-5КС с погрешностью измерений ±10 г. Средний вес определяли по завешиванию 100 особей в 5 повторах. В качестве погрешности на воду и слизь брали 2 %. Кормление рыб осуществляли с применением комбикорма торговой марки Aquarex производства ОАО «Мелькомбинат» (г. Тверь). Нормы внесения гаприна в состав кормов для радужной форели были определены исходя из исследований, проведенных на других видах рыб, и составили 4 % (опыт 1) и 7 % (опыт 2) от массы корма. Перед началом эксперимента обе группы рыб кормили кормом группы контроля. Для максимальной достоверности полученных данных комбикорма группы опыта произведены на основе кормов группы контроля. Показатели корма для групп опыта и контроля приведены в табл. 1.
Таблица 1
Table 1
Показатели контрольного корма для радужной форели
и корма с внесением гаприна в количестве 4 и 7 % от массы корма
Indicators of the control feed for rainbow trout
and feed with the addition of gaprin in the amount of 4 and 7 % by weight of the feed
|
Показатель качества |
Единицы измерения |
Контроль |
Опыт 1 |
Опыт 2 |
|
Влажность |
% |
6,44 |
6,2 |
6,3 |
|
Сырой протеин |
44,00 |
44,11 |
||
|
Сырой жир |
23,00 |
23,08 |
23,05 |
|
|
Сырая клетчатка |
1,29 |
1,32 |
1,42 |
|
|
Сырая зола |
5,6 |
5,8 |
4,9 |
|
|
Лизин |
% СВ |
3,23 |
3,29 |
3,4 |
|
Метионин |
0,83 |
0,81 |
0,84 |
|
|
Треонин |
1,80 |
1,72 |
||
|
Аргинин |
2,2 |
2,15 |
2,1 |
|
|
Изолейцин |
1,50 |
1,48 |
1,54 |
|
|
Валин |
2,29 |
2,19 |
2,08 |
|
|
Гистидин |
1,27 |
1,32 |
1,34 |
|
|
Ca |
мг/кг |
1,3 |
1,28 |
|
|
P |
1,1 |
1,2 |
||
|
Гаприн |
% от массы корма |
0 |
4 |
7 |
В качестве гаприна (белка микробиологического синтеза) выступал продукт под торговым наименованием «Инноприн» производства ООО «Биопрактика» (2023 г.). Количественные показатели белкового продукта представлены в табл. 2.
Таблица 2
Table 2
Количественные показатели и аминокислотный состав гаприна
Quantitative indicators and amino acid composition of gaprin
|
Показатель |
Единицы измерения |
Значение |
|
Влажность |
% |
7,2 |
|
Сырой протеин |
69,8 |
|
|
Сырой жир |
8,4 |
|
|
Сырая зола |
6,3 |
|
|
Cu |
мг/кг |
203,3 |
|
Zn |
95 |
|
|
Mo |
4,8 |
|
|
Аспаргиновая кислота + аспаргин |
% СВ |
5,5 |
|
Треонин |
2,8 |
|
|
Серин |
2,1 |
|
|
Глутаминовая кислота + глутамин |
7 |
|
|
Глицин |
3,5 |
|
|
Аланин |
4,6 |
|
|
Цистеин |
0,6 |
|
|
Валин |
3,9 |
|
|
Метионин |
1,8 |
|
|
Изолейцин |
3 |
|
|
Лейцин |
5 |
|
|
Тирозин |
2,5 |
|
|
Фенилаланин |
2,9 |
|
|
Гистидин |
1,8 |
|
|
Лизин |
3,7 |
|
|
Аргинин |
4 |
|
|
Пролин |
2,6 |
Перед отбором биологического материала рыба анестезировалась в растворе MS-222 в дозировке 10 мг/л. Отбор крови производился из задней полой вены у 10 особей из каждой экспериментальной группы. Изготовление и окрашивание мазков по Романовскому – Гимзе производилось согласно стандартным методикам [10]. На полученных препаратах производился подсчет относительного числа лимфоцитов, моноцитов, нейтрофилов, базофилов и тромбоцитов. Ткань среднего отдела кишечника и печени для гистологических исследований отбиралась сразу после вскрытия рыб и оценки ихтиопатологического состояния. Образцы ткани фиксировались в 4 %-м нейтральном формалине в течение 24 ч. Ткани дегидратировались в ряду градуированных спиртов и заливались в парафин согласно стандартной методике [11]. Срезы (4 мкм) окрашивались гематоксилином и эозином и исследовались на световом микроскопе Olympus BX53 (Olympus Corporation, Япония, Токио) с окулярными насадками CarlZeiss ERc 5s (Zeiss, Германия, Оберкохен) и ToupCam 16.0 MP (ToupTek Photonics, Китай) с использованием программного обеспечения ZEN lite (Zeiss, Германия) и ToupCam view 16.0 (ToupTek Photonics, Китай). Данные сравнения анализируемых переменных представлены в виде средних ±SD. Статистическая достоверность определялась с использованием непараметрических тестов (тест Краскела – Уоллиса, U-тест Манна – Уитни). Значение p < 0,05 было принято как статистически достоверное. Экономическая эффективность выращивания радужной форели рассчитана по методике, предложенной МСХ СССР и ВАСХНИЛ [12].
Результаты и обсуждение
В течение всего срока эксперимента гидрохимические параметры воды находились на оптимальном для роста радужной форели уровне. Мониторинг поведения и клинического состояния рыбы в контрольных и опытных садках показал отсутствие существенных нарушений. По результатам 90-суточного кормления производилось измерение рыбоводно-биологических показателей. В результате исследования было установлено, что группа рыб, получавшая в составе корма белок микробиологического происхождения в количестве 4 %, не демонстрировала достоверных различий по сравнению с контролем по показателям относительного прироста и кормового коэффициента (табл. 3).
Table 3
Рыбоводно-биологические показатели радужной форели групп контроля и опыта
Fish-breeding and biological indicators of rainbow trout of control and experimental groups
|
Показатель |
Контроль |
Опыт 1 |
Опыт 2 |
|
Масса начальная, г |
300 ± 19,6 |
300 ± 19,6 |
300 ± 19,6 |
|
Масса конечная, г |
673 ± 42,3 |
704 ± 37,4 |
628 ± 39,8* |
|
Абсолютный прирост, г |
373 |
404 |
328 |
|
Среднесуточный прирост, г |
4,14 |
4,48 |
3,64 |
|
Кормовой коэффициент, ед. |
1,19 |
1,1 |
1,34* |
|
Выживаемость, % |
96,87 |
97,72 |
96,34 |
* Здесь и далее: значения, выделенные жирным, указывают на статистические различия между группами. Значение p < 0,05 из теста Краскела – Уоллиса.
Внесение в состав корма гаприна в количестве 7 % приводило к значимому снижению среднесуточного прироста и увеличению кормового коэффициента. В процессе эксперимента все показатели крови находились в пределах биологических норм для радужной форели (рис. 1).

а б
Рис. 1. Картина крови радужной форели в контрольной (а) и опытной группе 2 (б):
Не – нейтрофил; Тр – тромбоцит; Ли – лимфоцит. Шкала масштаба 15 мкм
Fig. 1. Blood pattern of rainbow trout in control (а) and experimental group 2 (б):
Не – neutrophil; Тр – platelet; Ли – lymphocyte. The scale scale is 15 microns
Изучение гематологических показателей рыб в опытных группах позволило установить у рыб из второй опытной группы (7 % гаприна от массы корма) значимое увеличение количества лимфоцитов (до 24,4 тыс./мкл), а также снижение концентрации гемоглобина (табл. 4).
Таблица 4
Table 4
Гематологические показатели контрольной и опытных групп
Hematological parameters of the control and experimental groups
|
Показатель |
Контроль |
Опыт 2 |
|
Эритроциты, 106/мкл |
1,21 ± 0,15 |
1,19 ± 0,12 |
|
Незрелые эритроциты, % |
2,99 ± 0,3 |
2,97 ± 0,5 |
|
Лейкоциты, 104/мкл |
2,11 ± 0,08 |
2,11 ± 0,08 |
|
Лимфоциты, % |
91,14 ± 0,33 |
91,31 ± 0,4 |
|
Моноциты, % |
2,54 ± 0,23 |
1,89 ± 0,17* |
|
Нейтрофилы, % |
4,63 ± 0,09 |
4,92 ± 0,13 |
|
Базофилы, % |
1,69 ± 0,15 |
1,89 ± 0,17 |
|
Тромбоциты, % |
1,34 ± 0,04 |
1,32 ± 0,18 |
* Указывает на статистическую значимость p < 0,05 между контрольной и экспериментальной группой из t-критерия Уэлча.
Другие гематологические показатели не демонстрировали значимых различий. Исследование гистологических препаратов тканей среднего отдела кишечника и печени опытных рыб позволило выявить ряд нарушений. На гистологических препаратах среднего отдела кишечника просматривались следующие структуры: просвет кишечника, слизистая оболочка, собственная оболочка слизистой, подслизистый слой, мускульная оболочка и серозная оболочка. Состояние кишечника контрольной группы не имело значительных отклонений [13].
На препаратах кишечника рыбы из опытной группы 1 также не наблюдалось значимых изменений. При этом в данной группе было выявлено увеличение числа бокаловидных клеток, обнаруживаемое на некоторых участках слизистой. В целом секреторная активность кишечника в контроле и опытной группе 1 находится в норме. В образцах опытной группы 2 были обнаружены значительные структурные отклонения в кишечнике, которые заключались в изменении толщины подслизистой оболочки, деградации эпителиальных клеток слизистой кишечника, а также нарушении структуры собственной слизистой оболочки и присутствии большого числа лимфоцитов. Данные изменения обнаруживались на большей части препаратов слизистой кишечника. Структурные элементы ткани печени радужной форели включали гепатоциты, синусоидные капилляры, печеночные сосуды и желчные протоки (рис. 2, а).

а б
Рис. 2. Гистология печени радужной форели в контрольной (а) и опытной группе 2 (б):
ЖП – желчная протока; Яг – ядро гепатоцита; Си – синусоидный капилляр;
Ва – вакуолизация. Шкала масштаба 25 мкм
Fig. 2. Histology of the liver of rainbow trout in control (а) and experimental group 2 (б):
ЖП – bile duct; Яг – hepatocyte nucleus; Си – sinusoidal capillary;
Ва – vacuolization. A jackal scale of 25 microns
Структура ткани органа в контроле и группе опыт 1 соответствовала норме. На отдельных участках среза обнаруживались единичные гепатоциты с вакуолями. Печень рыб из опытной группы 2 имела более значимые изменения, в частности, по всей площади среза наблюдалось расширение синусоидных капилляров, которые были заполнены эритроцитами (рис. 2, б). Также было выявлено появление небольших очагов вакуолизации клеток. Данные вакуоли имели хромофобное содержимое и неровные границы. В паренхиме органа встречались гепатоциты с пикнотическими ядрами и наблюдался некроз отдельных клеток. По результатам изучения гистологических показателей кишечника и печени рыб можно сделать вывод, что внесение в корма белка микробиологического происхождения в количестве 7 % может оказывать негативное влияние на состояние органов желудочно-кишечного тракта. Следует отметить, что белковая масса гаприна содержит большое количество меди и цинка [14]. Высокие концентрации данных элементов в корме могут приводить к нарушениям структуры желудочно-кишечного тракта
и печени, а также оказывать негативное влияние на перевариваемость пищи [15]. В существующих работах по изучению включения белков микробиологического происхождения в корма наблюдается значительный разброс используемых концентраций и наблюдаемых эффектов. Так, в опытах на молоди сибирского осетра [16] отрицательные результаты ввода гаприна проявлялись при 20 % ввода данного компонента в состав комбикормов. При этом ввод подобного продукта в состав стартовых кормов может быть значительно выше, чем его содержание в составе продукционного корма, вследствие короткого промежутка кормления, кроме того, в работе [16] не описаны составы некоторых микроэлементов в премиксах. Аналогичные результаты определялись во время коротких промежутков откорма малька сиговых рыб [17] с учетом отсутствия разницы при введении 10 и 15 % гаприна в состав стартовых комбикормов. В обзоре различного опыта использования гаприна в аквакультуре [18] описывается его введение для лососевых видов рыб в количестве 10 % на сеголетках, однако в работе не описана возможность применения меньших дозировок на продукционных кормах. Полученные в данной работе результаты частично согласуются с приведенными данными. В рамках длительного опыта было установлено, что гаприн в концентрации 4 % от массы корма не приводит к ухудшению скорости роста, а также патологическим нарушениям у годовиков радужной форели. Для определения экономической эффективности применения гаприна в составе комбикормов использовался коэффициент оплаты корма, который ниже кормового коэффициента на 3–5 %. Так, кормовой коэффициент для группы контроля составил 1,19, для группы опыта 1 – 1,1, а для группы опыта 2 – 1,34. Оценочная стоимость корма для контрольной группы составляет 155 000 руб./т, опыт 1 – 147 000 руб./т, опыт 2 – 142 000 руб./т. Стоимость корма формируется исходя из сырьевой стоимости компонентов комбикорма. Вследствие замены рыбной муки гаприном, обладающим более низкой стоимостью, общая стоимость опытных кормов снижалась. В группе контроля стоимость набора одного килограмма биомассы составляет 184,45 руб./кг, в группе опыта 1 – 161,7 руб./кг, а в группе опыта 2 – 190,28 руб./кг. Таким образом, стоимость одного килограмма прироста биомассы при использовании кормов с добавлением гаприна в концентрации 4 % ниже контроля на 12,33 %, а для кормов с добавлением гаприна в концентрации 7 % выше на 3,16 %. Проведенное исследование позволило подтвердить эффективность применения гаприна в составе комбикормов для радужной форели и определить оптимальный процент ввода.
Выводы
1. Гаприн (белок микробиологического синтеза, торговая марка «Инноприн») при 4 %-м введении в состав комбикормов для радужной форели (Oncorhynchus mykiss) не вызывает повышенной смертности и не имеет токсических эффектов.
2. Гаприн при 7 %-м введении в состав комбикормов для радужной форели вызывает снижение кормового коэффициента, а также негативно влияет на клиническую картину крови, оказывает значительное негативное действие на печень и кишечник рыб.
3. Применение гаприна при 4 %-м введении в состав комбикормов позволяет снизить стоимость комбикорма и стоимость одного килограмма прироста биомассы до 161,7 руб./кг.
Для установления причин негативного воздействия больших концентраций гаприна на радужную форель необходимо проведение дополнительных исследований, включающих оценку широкого спектра физиологических показателей.
1. Скляров В. Я. Корма и кормление рыб в аквакультуре. М.: Изд-во ВНИРО, 2008. 150 с.
2. Щербина М. А., Гамыгин Е. А. Кормление рыб в пресноводной аквакультуре. М.: Изд-во ВНИРО, 2006. 360 с.
3. Жиенбаева С. Т., Ермуканова А. М. Использование нетрадиционного сырья в комбикормах для прудовых рыб // Современные научные исследования и разработки (Modern Research and Development): материалы Междунар. (заоч.) науч.-практ. конф. (Прага, 21 марта 2021 г.). Нефтекамск: НИЦ «Мир науки», 2019. С. 30–37.
4. Баканева Ю. М., Садлер Д.-А. А., Пономарев С. В. Эффективность использования комбинированных кормов различной жирности и состава жирных кислот при выращивании осетровых рыб // V Ежегод. науч. конф. студентов и аспирантов базовых кафедр Юж. науч. центра РАН (Ростов-на-Дону, 8–27 апреля 2009 г.): тез. докл. Ростов н/Д., 2009. С. 7–8.
5. Козлова Т. В., Дмитрович Н. П. Влияние новых растительных компонентов комбикормов на биохимические показатели крови ленского осетра (Acipenser baeri (Brandt)) // Вестн. Полес. гос. ун-та. Сер. природоведческих наук. 2023. № 1. С. 54–60.
6. Кононова С. В, Муранова Т. А., Зинченко Д. В., Белова Н. А., Мирошников А. И. Биотехнологические подходы при использовании белков рапса и сои в кормах аквакультуры лососевых рыб // Биотехнология. 2016. Т. 32. № 5. С. 57–68.
7. Булгаков С. П., Гаврилов Н. Н. Технология получения кормовой биомассы гаприн и реальность промышленной реализации на территории России // Инно-вации: перспективы, проблемы, достижения. 2013. С. 191–196.
8. Тимошина Л. А. Использование гаприна в кормах для радужной форели // Белковые продукты микробиосинтеза в кормлении рыб и другие вопросы интенсивного рыбоводства: сб. науч. тр. ГосНИОРХ. Л.: Ленуприздат, 1991. Т. 306. С. 47–54.
9. Фомин А. В. Использование гаприна и ферменто-лизата БВК в стартовом корме для молоди кеты // Белковые продукты микробиосинтеза в кормлении рыб и другие вопросы интенсивного рыбоводства: сб. науч. тр. ГосНИОРХ. Л.: Ленуприздат, 1991. Т. 306. С. 67–75.
10. Иванова Н. Т. Атлас клеток крови рыб. М.: Лег. и пищ. пром-сть, 1983. 110 с.
11. Suvarna K. S., Layton C., Bancroft J. D. Bancroft's theory and practice of histological techniques. Amsterdam: Elsevier health sciences, 2018. 573 p.
12. Методика определения экономической эффективности использования в сельском хозяйстве результатов научно-исследовательских и опытно-конструкторских работ, новой техники, изобретений и рационализаторских предложений. М.: Колос, 1980. 112 с.
13. Simakov Y. G., Ponomarev A. K., Nikiforov-Nikishin D. L., Kochetkov N. I. Histological examination of the young Oncorhynchus mykiss intestines using the feed with chelated and probiotic supplements // Brazilian Journal of Biology. 2022. V. 15 (84). e265121. DOI:https://doi.org/10.1590/1519-6984.265121.
14. Зенкович П. А., Литвиненко А. И., Литвиненко Л. И., Зенкович Р. В., Корентович М. А. Общий биохимический и аминокислотный составы тканей личинок и мальков муксуна Coregonus muksun Pallas, 1814 и чира Coregonus nasus Pallas, 1776 при подращивании на стартовых искусственных кормах, обогащенных бактериальной биомассой // Journal of Agriculture and Environment. 2024. № 6 (46). Порядковый номер 4. DOI:https://doi.org/10.60797/JAE.2024.46.8
15. Гаврилин К. В., Никифоров-Никишин Д. Л., Ко-четков Н. И., Смородинская С. В. Гистопатология костистых рыб: учеб.-практ. пособие. Курск: Деловая полиграфия, 2023. 199 с.
16. Zenkovich P. A., Korentovich M. A., Litvinenko A. I. Influence of Feeding Artificial Starter Fodder Enriched with Gaprin on the Content of Trace Elements in Early Juvenile Siberian Sturgeon // Journal of Agriculture and Environment. 2023. N. 11 (39). DOI:https://doi.org/10.23649/JAE.2023.39.21.
17. Остроумова И. Н., Костюничев В. В., Лютиков А. А., Богданова В. А., Шумилина А. К., Данилова Т. П., Филатова Т. А. Включение в стартовые корма для сиговых рыб (Coregonidae) бактериальной биомассы и белковых гидролизатов // Вопр. рыболовства. 2018. Т. 19. № 1. С. 82–98.
18. Литвиненко П. А. Использование биомассы ме-танокисляющих бактерий (гаприна) в кормлении осетровых видов рыб // Актуальные вопросы науки и хозяйства: новые вызовы и решения: cб. материалов IV Студенч. науч.-практ. конф. (Тюмень, 17–19 марта 2021 г.). Тюмень: Изд-во Гос. аграр. ун-та Сев. Зауралья, 2021. Т. 3. С. 619–625.
















